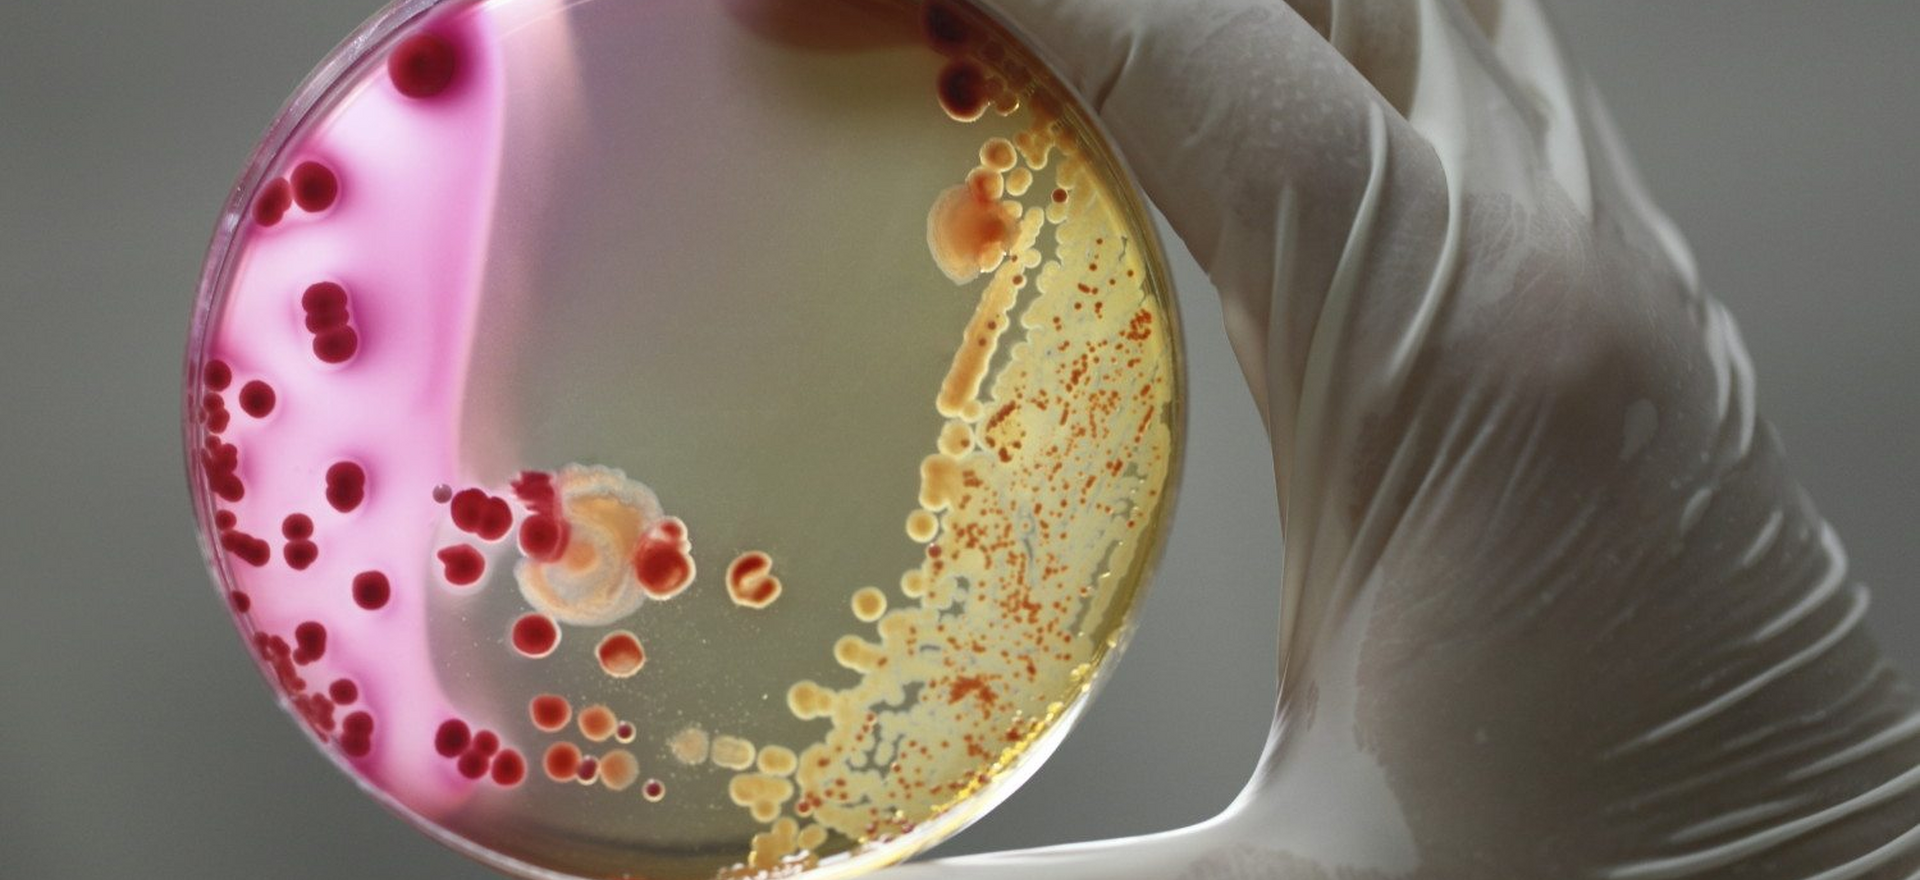

Бактериологические исследования – это лабораторные анализы, позволяющие выявить бактериальные инфекции, определить возбудителя заболевания и подобрать эффективное лечение с помощью антибиотикограммы.
Когда требуются бактериологические исследования?
При инфекциях дыхательных путей, мочеполовой системы, кожи, желудочно-кишечного тракта. В случаях диагностики бактериальных инфекций (стафилококк, стрептококк, кишечная палочка, хеликобактер пилори). Для определения устойчивости бактерий к антибиотикам, контроля эффективности лечения. При выявлении инфекций, передающихся половым путём (гонорея, хламидиоз, уреаплазмоз).
Виды бактериологических исследований
- Посев крови – выявление сепсиса, бактериального эндокардита.
- Посев мочи (бакпосев мочи) – диагностика инфекций мочевыводящих путей.
- Посев кала – обнаружение кишечных инфекций (сальмонеллёз, дизентерия).
- Посев мокроты – диагностика туберкулёза, пневмонии, бронхитов.
- Посев мазков (из зева, носа, влагалища, уретры) – выявление возбудителей респираторных и урогенитальных инфекций.
- Посев на Helicobacter pylori – диагностика бактериального гастрита, язвенной болезни.
Как проходит исследование?
Забор материала зависит от вида анализа: кровь, моча, кал, мокрота или мазки помещаются в питательную среду для выращивания бактерий. Через 3–7 дней проводится идентификация возбудителя и тестирование чувствительности к антибиотикам.
Основные преимущества бактериологического исследования в Беларуси
Точная диагностика инфекционных заболеваний с определением возбудителя. Возможность подбора эффективного антибиотика, исключение ненужной терапии. Безболезненность, высокая точность, доступность исследования.
Белорусские медицинские центры оснащены современными лабораториями, обеспечивающими точную диагностику бактериальных инфекций с использованием чувствительных методов анализа. Опытные специалисты быстро и точно интерпретируют результаты.





